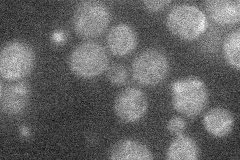
YGL146C

View description
Putative protein of unknown function; non-essential gene identified in a screen for mutants with increased levels of rDNA transcription; contains two putative transmembrane spans, but no significant homology to other known proteins
Localization:
Intensity:
Fold change:
Significance:
-
C’ GFP library in SD

below threshold16.56 -
N' NOP1pr-GFP in SD
below threshold14.477 -
N' TEF2pr-mCherry in SD

below threshold5.67079 -
N' NATIVEpr-GFP in SD

below threshold17.3487 -
N' TEF2pr-VC and Cyto-VN in SD

#N/A0 -
C’ GFP library in SD+DTT

cytosol17.361.04No -
C’ GFP library in SD+H2O2

cytosol17.291.04No -
C’ GFP library in Starvation Media

cytosol17.551.05No -
C’ GFP library on the background of Pup2-DaMP

below threshold -
C’ GFP library on the background of CCT mutant

below threshold17.04611.02879No
